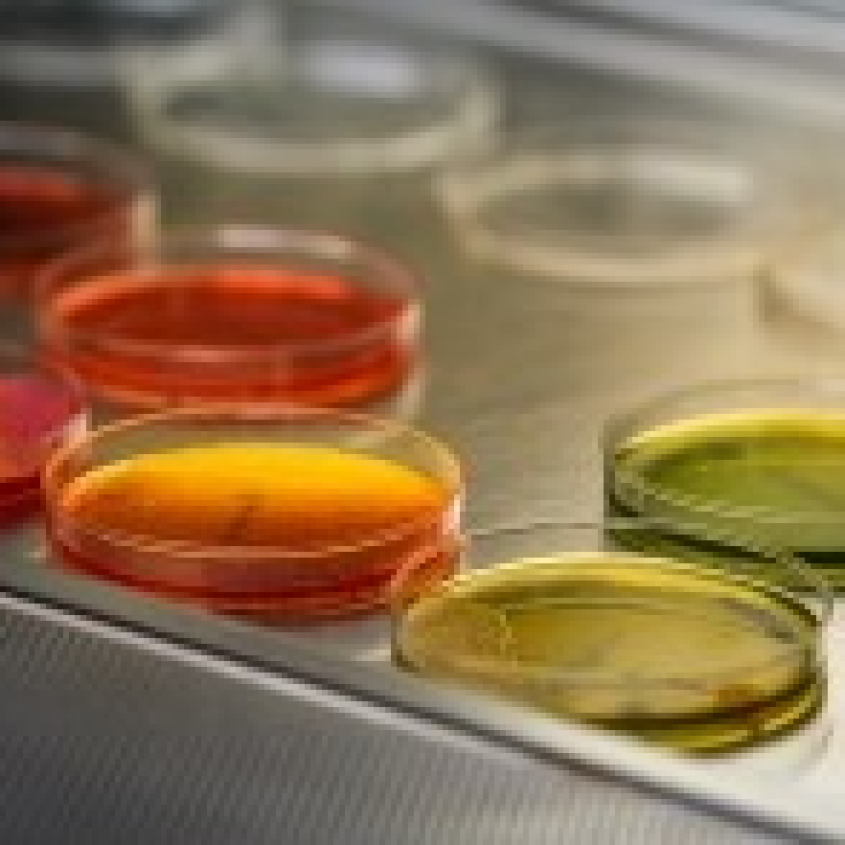
four petrie dishes of different colors

Mission
Our mission is to foster scientific discovery and exchange of ideas aimed at uncovering fundamental principles of immunology and microbiology to inform the next generation of preventions and therapeutics.
Our community of creative investigators and innovative educators is committed to inspiring and training the next generation of research scientists, teachers and veterinarians who will contribute to these areas.
Areas of focus
The department’s research and teaching missions are focused on the complex interplay between the microbe and host, recognizing that fundamental knowledge of the microbe and of immune development and function need to advance in concert to fully drive new insight at the host:microbe interface. Research is centered around three main concentrations: bacterial pathogenesis, molecular virology and immunology. Integration of these fields, by leveraging advanced technologies and collaborative research, is key to innovation that seeds the next generation of vaccines and therapeutics.
Research Spotlights